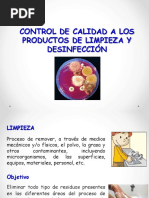

(Procesos Operacionales Estndares de Saneamiento)
POES
O SSOPs (Safety Standards & Operating Procedures)
Ing. Carlos Elas P.
�POES
Garantizan que los procedimientos de limpieza (1) y desinfeccin (2) se efecten correctamente. Se planifican y desarrollan a medida Al elaborar un POES se tienen que responder las siguientes preguntas fundamentales:
Qu limpiar y desinfectar? Cmo limpiar y desinfectar? Cundo limpiar y desinfectar? Quin limpia y desinfecta? Cmo limpiar y desinfectar? Con qu limpiar y desinfectar?
Ing. Carlos Elas P. 2
�Qu son los POES?
Son procedimientos escritos que describen y explican cmo realizar las tareas de limpieza y desinfeccin, de la mejor manera posible, antes y durante la elaboracin de alimentos. Esto incluye la definicin de los procedimientos de sanidad y la asignacin de responsables. POES es uno de los tres sistemas de aseguramiento de la calidad sanitaria en la alimentacin, junto con BPM (Buenas Prcticas de Manufactura) y HACCP (Anlisis de Riesgo de los Puntos Crticos de Control).
Ing. Carlos Elas P. 3
�Cules son los pasos?
1.
2.
3.
Asegurarse que nada quede afuera del POES. Con este paso se logra identificar qu limpiar y desinfectar. Determinar con qu frecuencia se limpiar y desinfectar. Esto sera cundo limpiar y desinfectar. Definir cmo limpiar y desinfectar. Para esto deben describirse todas las acciones a seguir para lograr la limpieza y desinfeccin correcta, incluso, en el caso de los equipos, cmo se deben desarmar para limpiar y desinfectar.
Ing. Carlos Elas P. 4
�Cules son los pasos?
4.
5.
6.
Elegir cuidadosamente los detergentes y desinfectantes ms apropiados a utilizar y especificar muy claramente sus condiciones de uso. Tambin deben considerarse las caractersticas de los cepillos o equipos automticos. Este paso permite conocer con qu limpiar y desinfectar. El operador a cargo de la tarea tiene que conocer previamente todo lo necesario para realizar el POES
�CAPACITACIN DEL PERSONAL
Es fundamental capacitar adecuadamente al personal que se hace responsable de la tarea en el POES. Es decir quin limpia y desinfecta. Es imprescindible para comer sin riesgos revalorizar laboralmente a la persona que se encarga de limpiar y desinfectar.
Ing. Carlos Elas P.
�ERRORES HABITUALES VINCULADOS A LA LIMPIEZA Y DESINFECCIN
1.
2.
3. 4. 5.
6.
7. 8. 9.
10.
Hacerlo apresuradamente y en momento inoportuno. Hacerlo en el lugar inadecuado. Mala eleccin de detergentes y desinfectantes. Mala preparacin de las soluciones de limpieza y desinfeccin. Utilizar accesorios en mal estado de conservacin. Aplicar temperaturas incorrectas en los procedimientos. Usar productos de limpieza y desinfeccin no aprobados. Mal almacenamiento de productos de limpieza y desinfeccin. Mtodos inadecuados o mal aplicados. Personal mal entrenado.
Ing. Carlos Elas P.
�REGISTRAR ACTIVIDADES Y ANTICIPAR MEDIDAS CORRECTIVAS
Todo lo que se haga en el POES debe de quedar registrado. Estos procedimientos exigen definir con anticipacin las medidas correctivas a aplicar cuando los resultados no sean los deseados, para evitar improvisaciones.
Ing. Carlos Elas P. 8
�PROLIFERACIN Y CONTROL DE PLAGAS
Por regla general, todo sector cercano a reas de elaboracin que propicie la proliferacin de plagas es, para dichas reas, un PCC (Punto Crtico de Control). As, la gestin preventiva del control de plagas se basa en un tratamiento indirecto que preserve la eficacia de POES.
Ing. Carlos Elas P. 9
�LE CORDON BLEU PERU
LIMPIEZA Y DESINFECCION
�ASPECTOS QUE CUBRE UN PROGRAMA SANITARIO
1. 2.
3. 4. 5.
Construccin del rea de operacin. Manejo y almacenamiento de materia prima. Higiene durante el proceso. Manejo del producto terminado. Control de plagas.
�ASPECTOS QUE CUBRE UN PROGRAMA SANITARIO
6.
7. 8.
9.
Manejo de desechos. Higiene de empleados. Higiene de equipos. Higiene del almacn (insumos y material de empaque y embalaje).
�LIMPIEZA
�Qu es limpieza?
LIMPIEZA es la eliminacin de la SUCIEDAD. Es decir la eliminacin de tierra, residuos de alimentos, polvo, grasa y otro material extrao de una superficie o rea de trabajo, para evitar que sobre ella crezcan las bacterias y microorganismos.
�Qu es la SUCIEDAD?
La SUCIEDAD se define como materia fuera del lugar, por ejemplo, la grasa en una caja de engranajes es un lubricante (necesario), pero la misma grasa sobre una superficie que entra en contacto con alimento se convierte en suciedad.
�COMPOSICION DE LA SUCIEDAD
Grasa Protena Carbohidratos (azcares y almidones) Minerales (incrustaciones y herrumbre)
�GRADOS DE LIMPIEZA
1.Visualmente limpio: Significa que
toda la suciedad visible ha sido removida; pero aunque no se observe suciedad, es posible que la haya; por ejemplo una fina pelcula de grasa o incrustaciones, que permiten el crecimiento de microorganismos. 2.Qumicamente limpio: Cuando las finas pelculas de grasa o incrustaciones o cualquier otro tipo de suciedad fueron removidas con el detergente.
�POR QUE LIMPIAMOS?
Para alcanzar los niveles de higiene, inocuidad y seguridad de los alimentos. Para mantener los equipos y utensilios en buenas condiciones y evitar que sean objeto de contaminacin. Para asegurar que los ambientes de trabajo no sean causante de contaminacin hacia el producto.
�METODOS DE LIMPIEZA
1.
2.
Manual con cepillo, paos: Se desmonta los equipos y se limpia pieza por pieza. La eficacia depende sobretodo de la meticulosidad del operario para el trabajo. Limpieza in situ(CIP): Utilizada para la limpieza de las tuberas en circuito cerrado, para lo cual se requiere de una velocidad de flujo mnima de 1.5 m/seg con flujo turbulento.
�METODOS DE LIMPIEZA
3. Limpieza con alta presin: Utilizada para remover la suciedad pegada de las hendiduras de los equipos. Si no se tiene cuidado en su aplicacin se formar aerosoles en el aire, desgaste de los equipos de produccin, dispersin de la suciedad e incremento de la humedad en la sala de proceso. 4. Limpieza a base de espuma: Se aplica detergente en forma de espuma(15-20min) y luego se enjuaga.
�LIMPIEZA CONTINUA EN AREAS DE PROCESO
Es importante limpiar o retirar la suciedad de un punto del proceso de produccin en cualquier momento que la suciedad se presente, sin tener que terminar el trabajo o que el encargado de la limpieza lo haga.
�LIMPIEZA CONTINUA EN AREAS DE PROCESO
Ejemplos prcticos: Cuando realice un pesado, alrededor de la balanza caen restos, entonces inmediatamente lo limpio. Cuando sobre la mesa de trabajo salpican o caen parte de los alimentos preparados, inmediatamente lo limpio. Veo restos de alimentos o deshechos, en el rea de trabajo, inmediatamente los recojo y limpio.
�FACTORES
QUE INFLUYEN EN LA LIMPIEZA
Temperatura
Tiempo Accin mecnica Concentracin.
�DETERGENTE
Es una sustancia qumica que se utiliza para eliminar la suciedad y la grasa de una superficie antes de desinfectar. Los detergentes se clasifican en: - Acidos. Alcalinos. Tensoactivos.
�Detergentes cidos
Son de dos tipos:
Inorgnicos: Ac. Ntrico, fosfrico, sulfmico (0,5% peso/volumen). Orgnicos: Ac. Actico, lctico, glucnico, tartrico(1-2% peso/volumen)
Ventaja: Solubilizan precipitados de sales inorgnicas. Inconvenientes: Corrosivos, irritantes para piel y mucosas.
�Detergentes alcalinos
Son de dos tipos:
Alta fuerza alcalina: Hidrxido sdico, ortosilicato sdico (1-5% peso/volumen) Fuerza alcalina media: Carbonato sdico, fosfato trisdico (1-10% peso/volumen)
Ventaja: solubilizan protena y grasa. Inconveniente: Forman precipitados en aguas de limpieza duras (alta concentracin de sales de calcio y magnesio)
�Detergentes tensoactivos
Ventajas: Buena capacidad de penetracin, compatible con detergentes alcalinos y cidos. Desventajas: Algunos son excesivamente espumosos. Concentraciones: 0,15% (peso/volumen) Existen detergentes con enzimas proteolticas, que hidrolizan residuos proteicos.
�DESINFECCION
�Qu es la DESINFECCION?
Destruccin de microorganismos mediante procedimiento fsicos o qumicos, aplicados a superficies limpias de forma que reduzca el nmero de microorganismos a un nivel tan pequeo que no causen dao.
�DESINFECTANTE
Agente de tipo fsico o qumico que mata a los microorganismos.
Los principios activos de los desinfectantes son:
1. 2. 3. 4.
cidos orgnicos (biodegradables). Amonio cuaternario. Cloro. Iodo
�OJO:
-
El agua caliente no necesariamente es un desinfectante, para que acte como tal tendra que estar en contacto con la superficie o material por un tiempo de 15 a 30 minutos o en su defecto encontrarse en el estado de vapor.
�FACTORES QUE AFECTAN LA DESINFECCION
Tiempo. Temperatura. Desinfectante usado. Concentracin. Microorganismos presentes. Ambiente (dureza del agua, suciedad, restos de detergentes).
�REQUISITOS DE UN DESINFECTANTE
1.
2. 3.
4.
5.
Efectividad para destruir microorganismos. No debe desarrollar resistencia. No ser corrosivo ni dar olor a ninguna superficie. Ser inodoro o no desprender olores desagradables. Seguro para el personal y el medio ambiente.
�Tipos de desinfectantes
Compuestos clorados:
Hipoclorito sdico, hipoclorito clcico, cloraminas. Concentraciones en agua 200 mg/L. Ventajas. Amplio espectro (bacterias, virus), no le afecta la dureza del agua. Inconvenientes: corrosivos, pierden actividad con presencia de materia orgnica, inestables en agua caliente, irritan la piel.
�Tipos de desinfectantes
Compuestos amonio cuaternario:
Lauril dimetil benzil amonio cloruro Concentraciones en agua <200 mg/L. Ventajas: No es corrosivo, no irrita la piel, no le afecta la dureza del agua. Inconvenientes: No es efectiva contra algunas bacetrias (Gram negativas)
�Tipos de desinfectantes
Compuestos iodoforos:
Concentraciones en agua 25 mg/L. Inconvenientes: ligeramente corrosivos, inestables en agua caliente (45C), pierden actividad con presencia de materia orgnica.
�Finalmente
�MEDIDAS QUE SE DEBEN TOMAR EN CUENTA
Los utensilios de limpieza y desinfeccin, no deben daar la superficie de los equipos y mobiliarios. Los fragmentos de cepillos, raspadores y otros materiales de limpieza no deben contaminar el alimento. Cada ambiente de trabajo deber contar con utensilios de limpieza y desinfeccin exclusivos (utensilios del bao no pueden ingresar a planta o de planta al bao).
�MEDIDAS QUE SE DEBEN TOMAR EN CUENTA
Cada equipo, utensilio y ambiente de proceso deber cumplir con un Programa de Limpieza y Desinfeccin. Los detergentes, desengrasantes y desinfectantes debern ser utilizados de acuerdo a la cantidad especificada en el cuadro de dosificacin. Todos los insumos para la limpieza y desinfeccin debern mantenerse en un lugar especifico dentro de la sala de proceso, debidamente identificados para evitar equivocaciones.